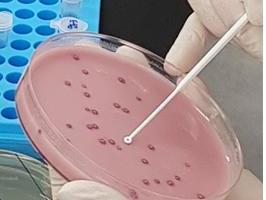

-
이예슬기자2018.09.26 22:28:15
-
이예슬기자2018.09.26 22:28:15
-
김지훈기자2018.09.26 22:28:15
-
"민족에 희망" vs "경제 아우성" 엇갈린 여야 추석민심
김난영기자2018.09.26 22:28:15
-
오애리기자2018.09.26 22:28:15
-
日 도카이2원전, 재가동 결정…쓰나미 피해 원전중 처음
조윤영기자2018.09.26 22:28:15
-
"날씬할 필요 없다"…탈코르셋 이어 '아이 웨이' 운동
손정빈기자2018.09.26 22:28:15
-
김정환기자2018.09.26 22:28:15
-
정창오기자2018.09.26 22:28:15
-
김진아2기자2018.09.26 22:28:15
-
일본 정부 "북일 정상회담, 납치문제 해결에 도움돼야"
이재준기자2018.09.26 22:28:15
-
'숙명여고 시험지 유출 의혹' 쌍둥이 내달초 경찰 출석
류병화기자2018.09.26 22:28:15
-
美공화, 캐버노 성추문 청문회에 성범죄 전담 여검사 동원
김재영기자2018.09.26 22:28:15
-
대형 사건 없던 평온한 추석…중요범죄 신고 11% 감소
이예슬기자2018.09.26 22:28:15
-
이예슬기자2018.09.26 22:28:15
-
프란치스코 교황 "중국 주교 최종 서품권, 나에게 있다"
이재준기자2018.09.26 22:28:15
-
인도 대법원, 13억 인구에 주민번호 부여 '합법' 판단
김재영기자2018.09.26 22:28:15
-
심동준기자2018.09.26 22:28:15
-
"말뫼의 눈물이 통영의 웃음으로"…폐조선소의 패자부활전
최희정기자2018.09.26 22:28:15
-
김현섭기자2018.09.26 22:28:15
-
최희정기자2018.09.26 22:28:15
-
보수 변호사단체 "김상조, 삼성 지주사 전환 압박" 내일 고발
강진아기자2018.09.26 22:28:15
-
"'동방불패' 린칭샤, 위자료 2900억원 받고 이혼설"
이재준기자2018.09.26 22:28:15
-
"대기업 면세점 매출액 전체 99% 차지…독과점 심각"
박영주기자2018.09.26 22:28:15
-
승마장서 탈출한 말, 왕복 8차로 1㎞ 질주 뒤 붙잡혀
하경민기자2018.09.26 22:28:15